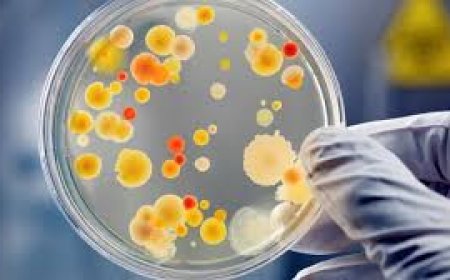

അങ്കണവാടികളിലെ പരിഷ്കരിച്ച ഭക്ഷണ മെനു സെപ്റ്റംബർ മുതൽ

തിരുവനന്തപുരം: അങ്കണവാടികളിലെ പരിഷ്കരിച്ച ഭക്ഷണ മെനു സെപ്റ്റംബർ എട്ടു മുതൽ നടപ്പിലാക്കും. ഇതിന്റെ ഭാഗമായി ഓരോ ജില്ലയിൽ നിന്നും ശിശുവികസന പദ്ധതി ഓഫിസർമാരും സൂപ്പർവൈസർമാരുമടങ്ങുന്ന നാലു വീതം ഉദ്യോഗസ്ഥരെ ഉൾപ്പെടുത്തി 56 പേർക്ക് സംസ്ഥാനതല പരിശീലനം നൽകിയെന്ന് വനിതാ ശിശുവികസന ഡയറക്റ്റർ അറിയിച്ചു.
സംസ്ഥാനതലത്തിൽ ടിഒടി പരിശീലനം ലഭ്യമായവർ ജില്ലകളിലെ ഫുഡ് ക്രാഫ്റ്റ് ഇൻസ്റ്റിറ്റ്യൂട്ടുകളും ഹോം സയൻസ് സ്ഥാപനങ്ങളുമായി സഹകരിച്ച് അങ്കണവാടി വർക്കർ, ഹെൽപ്പർ എന്നിവർക്ക് പരിശീലനം നൽകും. തുടർന്ന് ഇവർ സെക്റ്റർ, സബ് സെക്റ്റർ തലത്തിൽ 66240 അങ്കണവാടി പ്രവർത്തകരെ പരിശീലിപ്പിക്കും.